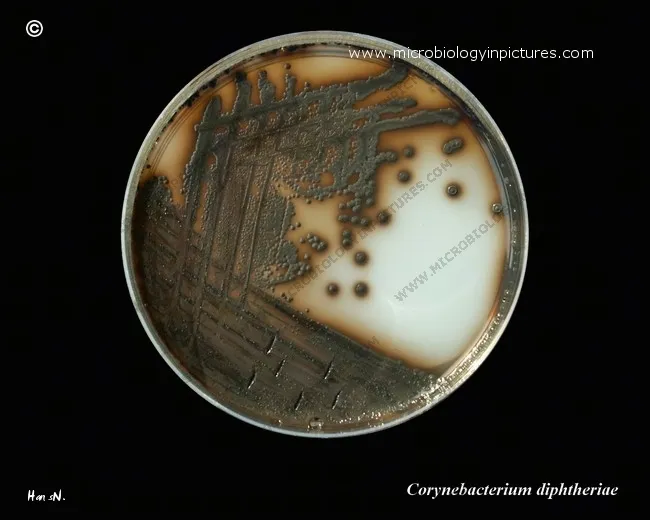
Corynebacterium diphtheriae on Tinsdale agar

Corynebacterium - The Club-Shaped Invaders
- Gram-positive, non-motile, club-shaped (coryneform) rods arranged in V/Y shapes or palisades.
- Contain metachromatic (Babes-Ernst) granules.
- Pathogenesis (C. diphtheriae): Diphtheria toxin, an A-B exotoxin, inhibits protein synthesis by ADP-ribosylating Elongation Factor 2 (EF-2).
- Clinical Triad: Pharyngitis with thick, gray pseudomembrane, "bull neck" (cervical lymphadenopathy), and low-grade fever.
- Systemic: Myocarditis, arrhythmias, and neuropathies.
- Diagnosis: Culture on Tellurite agar (black colonies) or Loeffler medium. Toxin detection via Elek test or PCR.
- Treatment: Antitoxin (most critical) + Erythromycin or Penicillin.
- Prevention: DTaP/Tdap toxoid vaccine.
⭐ The gene encoding the diphtheria toxin (tox) is introduced into C. diphtheriae by a lysogenic bacteriophage (β-prophage).

Diphtheria Toxin - The Protein Assassin
An A-B polypeptide exotoxin that irreversibly inhibits protein synthesis.
- Source: The tox gene is acquired via lysogenic conversion from a temperate β-prophage.
- Mechanism of Action:
- B (Binding) subunit attaches to the Heparin-Binding EGF-like growth factor (HB-EGF) receptor, which is abundant on cardiac and nerve cells.
- A (Active) subunit enters the cell cytoplasm.
- It catalyzes the ADP-ribosylation of Elongation Factor 2 (EF-2).
- This inactivation of EF-2 halts polypeptide chain elongation, leading to cell death.

⭐ The systemic effects (e.g., myocarditis, arrhythmias, neuropathies) are the direct result of toxin dissemination and its action on cells expressing the HB-EGF receptor. This is distinct from the local tissue necrosis that forms the pharyngeal pseudomembrane.
Diphtheria Clinical - From Grey Neck to Failing Heart
- Respiratory Diphtheria (Local Toxin)
- Presents 2-5 days post-exposure with sore throat, malaise, and low-grade fever.
- Hallmark: A dense, grey, adherent pseudomembrane forms over the tonsils and pharynx; bleeds if dislodged.
- Severe cases develop a "bull neck" from massive cervical adenopathy and edema, which can compromise the airway.

- Systemic Toxin Complications
- Myocarditis (1-2 wks): The most common cause of mortality. Can cause arrhythmias, heart block, and acute heart failure.
- Neuropathy (wks-mos): A progressive, symmetric polyneuropathy. Often starts with paralysis of the soft palate and diaphragm.
⭐ The diphtheria exotoxin irreversibly inactivates Elongation Factor-2 (EF-2) via ADP-ribosylation, which halts protein synthesis and causes cell death, especially in the heart and nerves.
Lab & Treatment - Tinsdale, Toxoids & Triage
-
Lab Diagnosis
- Culture on Tinsdale agar → black colonies with brown halos.
- Loeffler's medium → metachromatic (blue/red) granules.
- Elek test → detects toxin production (in vitro precipitation line).
-
Treatment & Prevention
- Triage Priority: Administer diphtheria antitoxin immediately on suspicion.
- Antibiotics: Penicillin G or erythromycin.
- Prevention: DTaP vaccine (diphtheria toxoid).
⭐ Crucial step: Antitoxin administration should NOT be delayed for lab confirmation. It neutralizes circulating toxin only.
High‑Yield Points - ⚡ Biggest Takeaways
- Gram-positive, club-shaped rods arranged in V or Y shapes ("Chinese letters").
- C. diphtheriae causes diphtheria via an exotoxin that inhibits protein synthesis by ADP-ribosylating EF-2.
- Presents with a grayish-white pseudomembrane in the pharynx and a "bull neck" due to lymphadenopathy.
- Systemic complications include myocarditis and neuropathy.
- Grows on tellurite agar (black colonies) and Loeffler's medium.
- The toxoid vaccine (in DTaP) is key for prevention.
Unlock the full lesson and continue reading
Signup to continue reading this lesson and unlimited access questions, flashcards, AI notes, and more